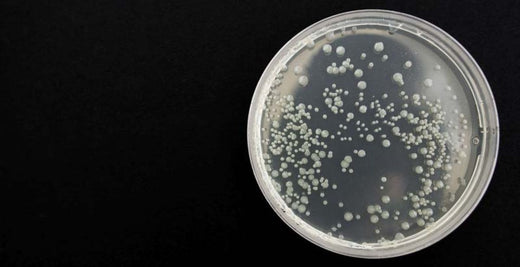

Scientific Information
Wet Foam Elution™ Yields Highly Concentrated Viable Target
This testing indicates the gentle nature of the Wet Foam Elution technology for retaining viability during the Concentrating Pipette's elution process using our standard PBS elution buffer.
Wet Foam Elution™ Yields Highly Concentrated Viable Target
This testing indicates the gentle nature of the Wet Foam Elution technology for retaining viability during the Concentrating Pipette's elution process using our standard PBS elution buffer.

Concentration of Extracelluar Vesicles via the Concentrating Pipette™ Select
The poster highlights recent method development by InnovaPrep for using the Concentrating Pipette to concentrate Extracellular Vesicles (EVs) from urine and serum.
Concentration of Extracelluar Vesicles via the Concentrating Pipette™ Select
The poster highlights recent method development by InnovaPrep for using the Concentrating Pipette to concentrate Extracellular Vesicles (EVs) from urine and serum.

Concentrating Pipette™ used by Delaware PHL to Screen Wastewater for Candida Auris Infections
Delaware Public Health Lab was one of the first labs to publish data tracking Candida Auris, an emerging global threat pathogen, using the InnovaPrep method. They presented a poster at the 2023 APHL...
Concentrating Pipette™ used by Delaware PHL to Screen Wastewater for Candida Auris Infections
Delaware Public Health Lab was one of the first labs to publish data tracking Candida Auris, an emerging global threat pathogen, using the InnovaPrep method. They presented a poster at the 2023 APHL...
Concentration for Virus Infectivity Assays - White Paper
White Paper - Concentration for Virus Infectivity Assays optimization tips specifically for concentrating enveloped viruses for infectivity assays using the Concentrating Pipette™
Concentration for Virus Infectivity Assays - White Paper
White Paper - Concentration for Virus Infectivity Assays optimization tips specifically for concentrating enveloped viruses for infectivity assays using the Concentrating Pipette™
Rapid Concentration to Improve Detection of Indicator Bacteria in Recreational Waters - White Paper
White Paper - Rapid Concentration to Improve Detection of Indicator Bacteria in Recreational Waters using the Concentrating Pipette
Rapid Concentration to Improve Detection of Indicator Bacteria in Recreational Waters - White Paper
White Paper - Rapid Concentration to Improve Detection of Indicator Bacteria in Recreational Waters using the Concentrating Pipette
Rapid Isolation of Exosomes in Urine Specimens - Application Note
Application Note - Concentration of Exosomes in Urine Specimens using the Concentrating Pipette
Rapid Isolation of Exosomes in Urine Specimens - Application Note
Application Note - Concentration of Exosomes in Urine Specimens using the Concentrating Pipette
Concentration of Spoilage Organisms in Carbonated Beverages - Application Note
Application Note - Rapid Concentration of Spoilage Organisms in Carbonated Beverages, including beer, for same shift detection using the Concentrating Pipette
Concentration of Spoilage Organisms in Carbonated Beverages - Application Note
Application Note - Rapid Concentration of Spoilage Organisms in Carbonated Beverages, including beer, for same shift detection using the Concentrating Pipette
Monitoring Bioaerosols in Critical Environments - Application Note
Application Note - Monitoring Bioaerosols in Critical Environments using AirPrep Samplers for same shift results
Monitoring Bioaerosols in Critical Environments - Application Note
Application Note - Monitoring Bioaerosols in Critical Environments using AirPrep Samplers for same shift results
Concentration of Foodborne Pathogens from Homogenized Foods - Application Note
Application note - Concentrating Foodborne Pathogens from Homogenized Foods using the Concentrating Pipette for same shift detection
Concentration of Foodborne Pathogens from Homogenized Foods - Application Note
Application note - Concentrating Foodborne Pathogens from Homogenized Foods using the Concentrating Pipette for same shift detection
Concentrating Bloodborne Pathogens from Whole Blood -Application Note
Application Note for Concentrating Bloodborne Pathogens from Whole Blood using the Concentrating Pipette.
Concentrating Bloodborne Pathogens from Whole Blood -Application Note
Application Note for Concentrating Bloodborne Pathogens from Whole Blood using the Concentrating Pipette.
Concentrating Pathogens from Raw and Primary Wastewater Influent - Application Note
Application Note - Concentrating Pathogens from Raw & Primary Wastewater Influent using the Concentrating Pipette.
Concentrating Pathogens from Raw and Primary Wastewater Influent - Application Note
Application Note - Concentrating Pathogens from Raw & Primary Wastewater Influent using the Concentrating Pipette.
Large Area Surface Sampling - Application Note
Application Note - Large-area Surface Sampling. A NASA developed protocol for concentrating surface sample wipes using the Concentrating Pipette.
Large Area Surface Sampling - Application Note
Application Note - Large-area Surface Sampling. A NASA developed protocol for concentrating surface sample wipes using the Concentrating Pipette.

